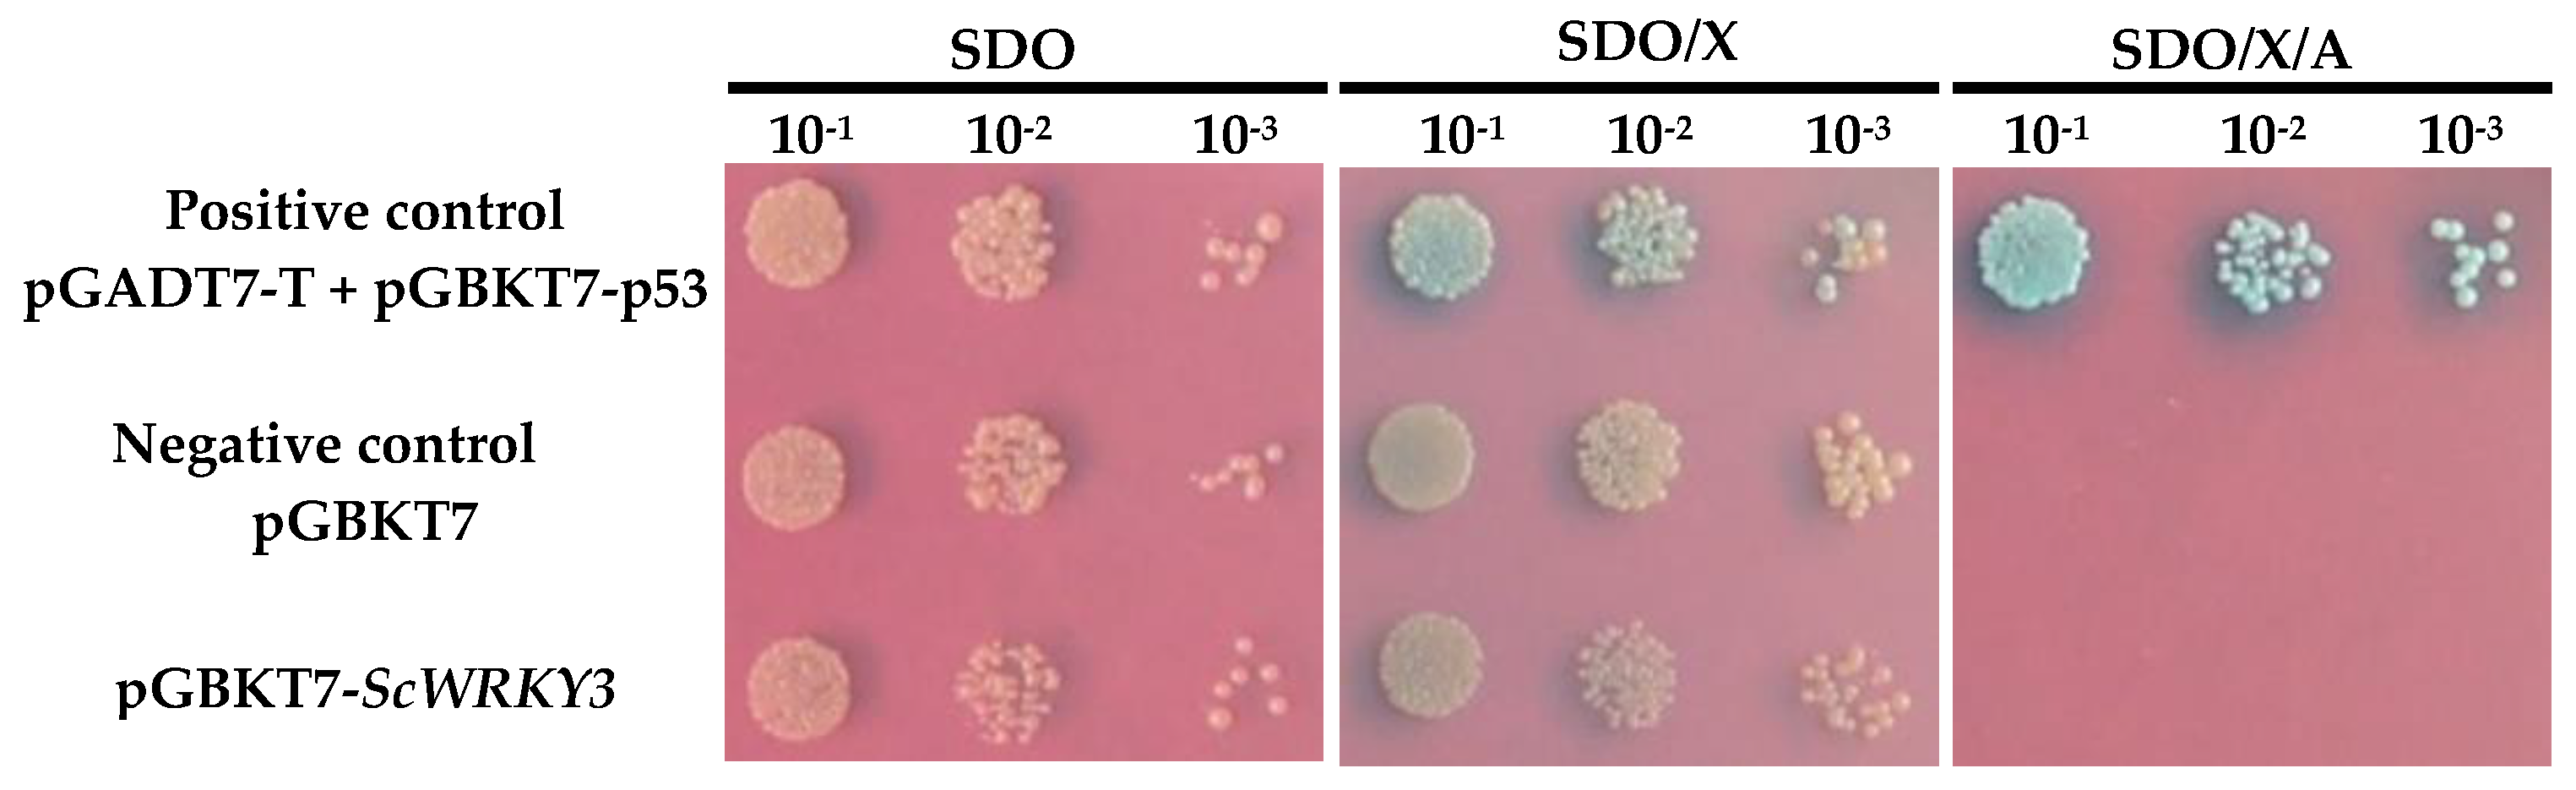
Ijms 19 04059 g005

Expression Characteristics and Functional Analysis of the ScWRKY3 Gene from Sugarcane
Abstract
:1. Introduction
2. Results
2.1. Bioinformatics Analysis of ScWRKY3 Gene
2.2. Subcellular Localization
2.3. Transcription Activation Activity of ScWRKY3
2.4. Interaction Between ScWRKY3 and ScWRKY4
2.5. Gene Expression Patterns of ScWRKY3 in Response to Various Stress Conditions
2.6. Transient Overexpression of ScWRKY3 in N. benthamiana Leaves
3. Discussion
4. Materials and Methods
4.1. Plant Materials and Treatments
4.2. RNA Extraction and First-strand cDNA Synthesis
4.3. Cloning, Sequencing, and Bioinformatic Analysis of the ScWRKY3 Gene
4.4. Subcellular Localization
4.5. Analysis of Transcriptional Activation of ScWRKY3 in Yeast Cells
4.6. Analysis of Interaction Between ScWRKY3 and ScWRKY4
4.7. Expression Patterns of ScWRKY3 in Sugarcane Tissues under Various Stresses
4.8. Transient Expression of ScWRKY3 in N. benthamiana
5. Conclusions
Supplementary Materials
Author Contributions
Funding
Conflicts of Interest
References
- Ulker, B.; Somssich, I.E. WRKY transcription factors: From DNA binding towards biological function. Curr. Opin. Plant Biol. 2004, 7, 491–498. [Google Scholar] [CrossRef] [PubMed]
- Jiang, J.J.; Ma, S.H.; Ye, N.H.; Jiang, M.; Cao, J.S.; Zhang, J.H. WRKY transcription factors in plant responses to stresses. J. Integr. Plant Biol. 2017, 59, 86–101. [Google Scholar] [CrossRef] [PubMed] [Green Version]
- Singh, K.B.; Foley, R.C.; Oñatesánchez, L. Transcription factors in plant defense and stress responses. Curr. Opin. Plant Biol. 2002, 5, 430–436. [Google Scholar] [CrossRef]
- Chen, L.G.; Song, Y.; Li, S.J.; Li, S.J.; Zhang, L.P.; Zou, C.S.; Yu, D.Q. The role of WRKY transcription factors in plant abiotic stresses. Biochim. Biophys. Acta 2012, 1819, 120–128. [Google Scholar] [CrossRef] [PubMed]
- Rushton, P.J.; Somssich, I.E.; Ringler, P.; Shen, Q.J. WRKY transcription factors. Trends Plant Sci. 2010, 15, 247–258. [Google Scholar] [CrossRef] [PubMed]
- Eulgem, T.; Rushton, P.J.; Robatzek, S.; Somssich, I.E. The WRKY superfamily of plant transcription factors. Trends Plant Sci. 2000, 5, 199–206. [Google Scholar] [CrossRef]
- Mohanta, T.K.; Park, Y.H.; Bae, H. Novel genomic and evolutionary insight of WRKY transcription factors in plant lineage. Sci. Rep. 2016, 6, 37309. [Google Scholar] [CrossRef] [PubMed]
- Chen, F.; Hu, Y.; Vannozzi, A.; Wu, K.C.; Cai, H.Y.; Qin, Y.; Mullis, A.; Lin, Z.G.; Zhang, L.S. The WRKY transcription factor family in model plants and crops. Plant Sci. 2018, 36, 1–25. [Google Scholar] [CrossRef]
- Ramamoorthy, R.; Jiang, S.Y.; Kumar, N.; Venkatesh, P.N.; Ramachandran, S. A comprehensive transcriptional profiling of the WRKY gene family in rice under various abiotic and phytohormone treatments. Plant. Cell Physiol. 2008, 49, 865–879. [Google Scholar] [CrossRef] [PubMed]
- Wei, K.; Chen, J.; Chen, Y.F.; Wu, L.J.; Xie, D.X. Multiple-strategy analyses of ZmWRKY subgroups and functional exploration of ZmWRKY genes in pathogen responses. Mol. Biosyst. 2012, 8, 1940–1949. [Google Scholar] [CrossRef] [PubMed]
- Muthamilarasan, M.; Bonthala, V.S.; Khandelwal, R.; Jaishankar, J.; Shweta, S.; Nawaz, K.; Prasad, M. Global analysis of WRKY transcription factor superfamily in Setaria identifies potential candidates involved in abiotic stress signaling. Front. Plant Sci. 2015, 6, 910. [Google Scholar] [CrossRef] [PubMed]
- Pandey, S.P.; Somssich, I.E. The role of WRKY transcription factors in plant immunity. Plant Physiol. 2009, 150, 1648–1655. [Google Scholar] [CrossRef] [PubMed]
- Mangelsen, E.; Kilian, J.; Berendzen, K.W.; Kolukisaoglu, U.H.; Harter, K.; Jansson, C.; Wanke, D. Phylogenetic and comparative gene expression analysis of barley (Hordeum vulgare) WRKY transcription factor family reveals putatively retained functions between monocots and dicots. BMC Genomics 2008, 9, 194. [Google Scholar] [CrossRef] [PubMed]
- Wei, X.A.; Yao, W.J.; Jiang, T.B.; Zhou, B.R. Identification of WRKY gene in response to abiotic stress from WRKY transcirption factor gene family of Arabidopsis thaliana. J. Northeast. For. Univ. 2016, 44, 45–48. [Google Scholar]
- Zhang, T.; Tan, D.; Zhang, L.; Zhang, X.; Han, Z. Phylogenetic analysis and drought-responsive expression profiles of the WRKY transcription factor family in maize. Agric. Gene 2017, 3, 99–108. [Google Scholar] [CrossRef]
- Wu, J.; Chen, J.B.; Wang, L.F.; Wang, S.M. Genome-wide investigation of WRKY transcription factors involved in terminal drought stress response in common bean. Front. Plant Sci. 2017, 8, 380. [Google Scholar] [CrossRef] [PubMed]
- Qiu, Y.Q.; Jing, S.J.; Fu, J.; Li, L.; Yu, D.Q. Cloning and analysis of expression profile of 13 WRKY genes in rice. Chin. Sci. Bull. 2004, 49, 2159–2168. [Google Scholar] [CrossRef]
- Wu, H.L.; Ni, Z.F.; Yao, Y.Y.; Guo, G.G.; Sun, Q.X. Cloning and expression profiles of 15 genes encoding WRKY transcription factor in wheat (Triticum aestivem L.). Prog. Nat. Sci. Mater. Int. 2008, 18, 697–705. [Google Scholar] [CrossRef]
- Dong, J.; Chen, C.H.; Chen, Z.X. Expression profiles of the Arabidopsis WRKY gene superfamily during plant defense response. Plant Mol. Biol. 2003, 51, 21–37. [Google Scholar] [CrossRef] [PubMed]
- Kim, K.C.; Lai, Z.; Fan, B.; Chen, Z. Arabidopsis WRKY38 and WRKY62 transcription factors interact with histone deacetylase 19 in basal defense. Plant Cell 2008, 20, 2357–2371. [Google Scholar] [CrossRef] [PubMed]
- Liu, D.L.; Leib, K.; Zhao, P.Y.; Kogel, K.H.; Langen, G. Phylogenetic analysis of barley WRKY proteins and characterization of HvWRKY1 and repressors of the pathogen-inducible gene HvGER4c. Mol. Genet. Genomics 2014, 289, 1331–1345. [Google Scholar] [CrossRef] [PubMed]
- Peng, Y.; Bartley, L.E.; Chen, X.W.; Dardick, C.; Chern, M.; Ruan, R.; Canlas, P.E.; Ronald, P.C. OsWRKY62 is a negative regulator of basal and Xa21-mediated defense against Xanthomonas orvzae pv. orvzae in rice. Mol. Plant 2008, 1, 446–458. [Google Scholar] [CrossRef] [PubMed]
- Berri, S.; Abbruscato, P.; Faivre-Rampant, O.; Brasileiro, A.C.; Fumasoni, I.; Satoh, K.; Kikuchi, S.; Mizzi, L.; Morandini, P.; Pè, M.E.; et al. Characterization of WRKY co-regulatory networks in rice and Arabidopsis. BMC Plant Biol. 2009, 9, 120. [Google Scholar] [CrossRef] [PubMed]
- Banerjee, A.; Roychoudhury, A. WRKY proteins: Signaling and regulation of expression during abiotic stress responses. Sci. World J. 2015, 807560. [Google Scholar] [CrossRef] [PubMed]
- Chen, R.K.; Xu, L.P.; Lin, Y.Q. Modern Sugarcane Genetic Breeding; China Agriculture Press: Beijing, China, 2011. [Google Scholar]
- Lambais, M.R. In silico differential display of defense-related expressed sequence tags from sugarcane tissues infected with Diazotrophic endophytes. Genet. Mol. Biol. 2001, 24, 103–111. [Google Scholar] [CrossRef]
- Liu, J.X.; Que, Y.X.; Guo, J.L.; Xu, L.P.; Wu, J.Y.; Chen, R.K. Molecular cloning and expression analysis of a WRKY transcription factor in sugarcane. Afr. J. Biotechnol. 2012, 11, 6434–6444. [Google Scholar]
- Wang, L.; Liu, F.; Dai, M.J.; Sun, T.T.; Su, W.H.; Wang, C.F.; Zhang, X.; Mao, H.Y.; Su, Y.C.; Que, Y.X. Cloning and expression characteristic analysis of ScWRKY4 gene in sugarcane. Acta Agron. Sin. 2018, 44, 1367–1379. [Google Scholar]
- Que, Y.X.; Su, Y.C.; Guo, J.L.; Wu, Q.B.; Xu, L.P. A global view of transcriptome dynamics during Sporisorium scitamineum challenge in sugarcane by RNAseq. PLoS ONE 2014, 9, e106476. [Google Scholar] [CrossRef] [PubMed]
- Chou, K.C.; Shen, H.B. A new method for predicting the subcellular localization of eukaryotic proteins with both single and multiple sites: Euk-mPLoc 2.0. PLoS ONE 2010, 5, e9931. [Google Scholar] [CrossRef] [PubMed]
- Ishiguro, S.; Nakamura, K. Characterization of a cDNA encoding a novel DNA-binding protein, SPF1, that recognizes SP8 sequences in the 5′ upstream regions of genes coding for sporamin and beta-amylase from sweet potato. Mol. Gen. Genet. 1994, 244, 563–571. [Google Scholar] [CrossRef] [PubMed]
- Eulgem, T.; Rushton, P.J.; Schmelzer, E.; Hahlbrock, K.; Somssich, I.E. Early nuclear events in plant defence signalling: Rapid gene activation by WRKY transcription factors. Embo J. 1999, 18, 4689–4699. [Google Scholar] [CrossRef] [PubMed]
- Liu, L.S.; White, M.J.; Macrae, T. Transcription factors and their genes in higher plants. FEBS J. 2010, 262, 247–257. [Google Scholar]
- Fan, Z.Q.; Tan, X.L.; Shan, W.; Kuang, J.F.; Lu, W.J.; Chen, J.Y. BrWRKY65, a WRKY transcription factor, is involved in regulating three leaf senescence-associated genes in Chinese flowering cabbage. Int. J. Mol. Sci. 2017, 18, 1228. [Google Scholar]
- Wan, Y.Q.; Mao, M.Z.; Wan, D.L.; Yang, Q.; Yang, F.Y.; Mandlaa; Li, G.J.; Wang, R.G. Identification of the WRKY gene family and functional analysis of two genes in Caragana intermedia. BMC Plant Biol. 2018, 18, 31. [Google Scholar] [CrossRef] [PubMed]
- Lee, H.; Cha, J.; Choi, C.; Choi, N.; Ji, H.S.; Park, S.R.; Lee, S.; Hwang, D.J. Rice WRKY11 plays a role in pathogen defense and drought tolerance. Rice 2018, 11, 5. [Google Scholar] [CrossRef] [PubMed]
- Wang, H.H.; Meng, J.; Peng, X.X.; Tang, X.K.; Zhou, P.L.; Xiang, J.H.; Deng, X.B. Rice WRKY4 acts as a transcriptional activator mediating defense responses toward Rhizoctonia solani, the causing agent of rice sheath blight. Plant Mol. Biol. 2015, 89, 157–171. [Google Scholar] [CrossRef] [PubMed]
- Fields, S.; Song, O. A novel genetic system to detect protein-protein interactions. Nature 1989, 340, 245. [Google Scholar] [CrossRef] [PubMed]
- Sébastien, B.; Li, J.; Palva, E.T. WRKY54 and WRKY70 co-operate as negative regulators of leaf senescence in Arabidopsis thaliana. J. Exp. Bot. 2012, 63, 2667–2679. [Google Scholar]
- Wang, X.T.; Zeng, J.; Li, Y.; Rong, X.L.; Sun, J.T.; Sun, T.; Li, M.; Wang, L.Z.; Feng, Y.; Chai, R.H.; et al. Expression of TaWRKY44, a wheat WRKY gene, in transgenic tobacco confers multiple abiotic stress tolerances. Front. Plant Sci. 2015, 6, 615. [Google Scholar] [CrossRef] [PubMed]
- Chi, Y.C.; Yang, Y.; Zhou, Y.; Zhou, J.; Fan, B.F.; Yu, J.Q.; Chen, Z.X. Protein-protein interactions in the regulation of WRKY transcription factors. Mol. Plant 2013, 6, 287–300. [Google Scholar] [CrossRef] [PubMed]
- Robatzek, S.; Somssich, I.E. Targets of AtWRKY6 regulation during plant senescence and pathogen defense. Genes Dev. 2002, 16, 1139–1149. [Google Scholar] [CrossRef] [PubMed]
- Popescu, S.C.; Popeseu, G.V.; Bachan, S.; Zhang, Z.; Gerstein, M.; Snyder, M.; Dinesh-Kumar, S.E. MAPK target networks in Arabidopsis thaliana revealed using functional protein microarrays. Genes Dev. 2009, 23, 80–92. [Google Scholar] [CrossRef] [PubMed]
- Zhou, L.; Wang, N.N.; Kong, L.; Gong, S.Y.; Li, Y.; Li, X.B. Molecular characterization of 26 cotton WRKY genes that are expressed differentially in tissues and are induced in seedlings under high salinity and osmotic stress. Plant Cell Tissue Org. Cult. 2014, 119, 141–156. [Google Scholar] [CrossRef]
- Bakshi, M.; Oelmüller, R. WRKY transcription factors: Jack of many trades in plants. Plant Signal. Behav. 2014, 9, e27700. [Google Scholar] [CrossRef] [PubMed]
- Bartels, D.; Sunkar, R. Drought and salt tolerance in plants. Crit. Rev. Plant Sci. 2005, 24, 23–58. [Google Scholar] [CrossRef]
- Qiao, Z.; Li, C.L.; Zhang, W. WRKY1 regulates stomatal movement in drought-stressed Arabidopsis thaliana. Plant Mol. Biol. 2016, 91, 53–65. [Google Scholar] [CrossRef] [PubMed]
- Jiang, Y.J.; Yu, D.Q. WRKY57 regulates JAZ genes transcriptionally to compromise Botrytis cinerea resistance in Arabidopsis thaliana. Plant Physiol. 2016, 171, 2771–2782. [Google Scholar] [CrossRef] [PubMed]
- Jones, J.D.; Dang, J.L. The plant immune system. Nature 2006, 444, 323–329. [Google Scholar] [CrossRef] [PubMed] [Green Version]
- Métraux, J.P.; Nawrath, C.; Genoud, T. Systemic acquired resistance. Euphytica 2002, 124, 23–243. [Google Scholar] [CrossRef]
- Katagiri, F. A global view of defense gene expression regulation—A highly interconnected signaling network. Curr. Opin. Plant Biol. 2004, 7, 506–511. [Google Scholar] [CrossRef] [PubMed]
- Kunkel, B.N.; Brooks, D.M. Cross talk between signaling pathways in pathogen defense. Curr. Opin. Plant Biol. 2002, 5, 325–331. [Google Scholar] [CrossRef]
- Chen, X.T.; Liu, J.; Lin, G.F.; Wang, A.; Wang, Z.G.; Lu, G.D. Overexpression of AtWRKY28 and AtWRKY75 in Arabidopsis enhances resistance to oxalic acid and Sclerotinia sclerotiorum. Plant Cell Rep. 2013, 32, 1589–1599. [Google Scholar] [CrossRef] [PubMed]
- Wang, H.H.; Hao, J.J.; Chen, X.J.; Hao, Z.N.; Wang, X.; Lou, Y.G.; Peng, Y.L.; Guo, Z.J. Overexpression of rice WRKY89 enhances ultraviolet B tolerance and disease resistance in rice plants. Plant Mol. Biol. 2007, 65, 799–815. [Google Scholar] [CrossRef] [PubMed]
- Qiu, D.Y.; Xiao, J.; Ding, X.H.; Xiong, M.; Cai, M.; Cao, Y.L.; Li, X.H.; Xu, C.G.; Wang, S.P. OsWRKY13 mediates rice disease resistance by regulating defense-related genes in salicylate- and jasmonate-dependent signaling. Mol. Plant-Microbe Interact. 2007, 20, 492–499. [Google Scholar] [CrossRef] [PubMed]
- Qiu, D.Y.; Xiao, J.; Xie, W.B.; Liu, H.B.; Li, X.H.; Xiong, L.Z.; Wang, S.P. Rice gene network inferred from expression profiling of plants overexpressing OsWRKY13, a positive regulator of disease resistance. Mol. Plant 2008, 1, 538–551. [Google Scholar] [PubMed]
- Zheng, Z.Y.; Mosher, S.L.; Fan, B.F.; Klessig, D.F.; Chen, Z.X. Functional analysis of Arabidopsis WRKY25 transcription factor in plant defense against Pseudomonas syringae. BMC Plant Biol. 2007, 7, 2. [Google Scholar] [CrossRef] [PubMed]
- Jiang, Y.; Deyholos, M.K. Functional characterization of Arabidopsis NaCl-inducible WRKY25 and WRKY33 transcription factors in abiotic stresses. Plant Mol. Biol. 2009, 69, 91–105. [Google Scholar] [CrossRef] [PubMed]
- Yokotani, N.; Sato, Y.; Tanabe, S.; Chujo, T.; Shimizu, T.; Okada, K.; Yamane, K.; Shimono, M.; Sugano, S.; Takatsuji, H.; et al. WRKY76 is a rice transcriptional repressor playing opposite roles in blast disease resistance and cold stress tolerance. J. Exp. Bot. 2013, 64, 5085–5097. [Google Scholar] [CrossRef] [PubMed] [Green Version]
- Liu, X.F.; Song, Y.Z.; Xing, F.Y.; Wang, N.; Wen, F.J. GhWRKY25, a group I WRKY gene from cotton, confers differential tolerance to abiotic and biotic stresses in transgenic Nicotiana benthamiana. Protoplasma 2015, 253, 1–17. [Google Scholar] [CrossRef] [PubMed]
- Wang, X.; Yan, Y.; Li, Y.Z.; Chu, X.Q.; Wu, C.G.; Guo, X.Q. GhWRKY40, a multiple stress-responsive cotton WRKY gene, plays an important role in the wounding response and enhances susceptibility to Ralstonia solanacearum infection in transgenic Nicotiana benthamiana. PLoS ONE 2014, 9, e93577. [Google Scholar] [CrossRef] [PubMed]
- Mukhtar, M.S.; Deslandes, L.; Auriac, M.; Marco, Y.; Somssich, I.E. The Arabidopsis transcription factor WRKY27 influences wilt disease symptom development caused by Ralstonia solanacearum. Plant J. 2008, 56, 935. [Google Scholar] [CrossRef] [PubMed]
- Su, Y.C.; Guo, J.L.; Ling, H.; Chen, S.S.; Wang, S.S.; Xu, L.P.; Allan, A.C.; Que, Y.X. Isolation of a novel peroxisomal catalase gene from sugarcane, which is responsive to biotic and abiotic stresses. PLoS ONE 2014, 9, e84426. [Google Scholar] [CrossRef] [PubMed]
- Li, H.; Gao, Y.; Xu, H.; Dai, Y.; Deng, D.Q.; Chen, J.M. ZmWRKY33, a WRKY maize transcription factor conferring enhanced salt stress tolerances in Arabidopsis. Plant Growth Regul. 2013, 70, 207–216. [Google Scholar] [CrossRef]
- Scarpeci, T.E.; Zanor, M.I.; Zanor, M.I.; Mueller-Roeber, B.; Valle, E.M. Overexpression of AtWRKY30 enhances abiotic stress tolerance during early growth stages in Arabidopsis thaliana. Plant Mol. Biol. 2013, 83, 265–277. [Google Scholar] [CrossRef] [PubMed]
- Marchlerbauer, A.; Bo, Y.; Han, L.Y.; He, J.; Lanczycki, C.J.; Lu, S.N.; Chitsaz, F.; Derbyshire, M.K.; Geer, R.C.; Gonzales, N.R.; et al. CDD/SPARCLE: Functional classification of proteins via subfamily domain architectures. Nucleic Acids Res. 2017, 45, 200–203. [Google Scholar] [CrossRef] [PubMed]
- Gasteiger, E.; Hoogland, C.; Gattiker, A.; Duvaud, S.; Wilkins, M.R.; Appel, R.D.; Bairoch, A. Protein identification and analysis tools on the ExPASy server. In The Proteomics Protocols Handbook; Humana Press: New York, NY, USA, 2005; pp. 571–607. [Google Scholar]
- Combet, C.; Blanchet, C.; Geourjon, C.; Deléage, G. NPS@: Network protein sequence analysis. Trends Biochem. Sci. 2000, 25, 147–150. [Google Scholar] [CrossRef]
- Petersen, T.N.; Brunak, S.; Heijne, G.; Nielsen, H. SignalP 4.0: Discriminating signal peptides from transmembrane regions. Nat. Methods 2011, 8, 785–786. [Google Scholar] [CrossRef] [PubMed]
- Nielsen, H. Predicting secretory proteins with SignalP. Methods Mol. Biol. 2017, 1611, 59–73. [Google Scholar] [PubMed]
- Krogh, A.; Larsson, B.; Heijne, G.V.; Sonnhammer, E.L.L. Predicting transmembrane protein topology with a hidden markov model: Application to complete genomes. J. Mol. Biol. 2001, 305, 567–580. [Google Scholar] [CrossRef] [PubMed]
- Kumar, S.; Stecher, G.; Tamura, K. MEGA7: Molecular evolutionary genetics analysis version 7.0 for bigger datasets. Mol. Biol. Evol. 2016, 33, 1870–1874. [Google Scholar] [CrossRef] [PubMed]
- Wang, C.; Deng, P.; Chen, L.; Wang, X.; Ma, H.; Hu, W.; Yao, N.C.; Feng, Y.; Chai, R.H.; Yang, G.X.; et al. A wheat WRKY transcription factor TaWRKY10 confers tolerance to multiple abiotic stresses in transgenic tobacco. PLoS ONE 2013, 8, e65120. [Google Scholar] [CrossRef] [PubMed]
- Curtis, M.D.; Grossniklaus, U. A gateway cloning vector set for high-throughput functional analysis of genes in planta. Plant Phyosiol. 2003, 133, 462–469. [Google Scholar] [CrossRef] [PubMed]
- Hwang, I.S.; Hwang, B.K. Requirement of the cytosolic interaction between pathogenesis-related protein10 and leucine-rich repeat protein1 for cell death and defense signaling in pepper. Plant Cell 2012, 24, 1675–1690. [Google Scholar]
- Fan, Z.Q.; Kuang, J.F.; Fu, C.C.; Shan, W.; Han, Y.C.; Xiao, Y.Y.; Ye, Y.J.; Lu, W.J.; Lakshmanan, P.; Duan, X.W.; et al. The banana transcriptional repressor MaDEAR1 negatively regulates cell wall-modifying genes involved in fruit ripening. Front. Plant Sci. 2016, 7, 1021. [Google Scholar] [CrossRef] [PubMed]
- Shen, C.J.; Wang, S.K.; Bai, Y.H.; Wu, Y.R.; Zhang, S.N.; Chen, M.; Guilfoyle, T.J.; Wu, P.; Qi, Y.H. Functional analysis of the structural domain of ARF proteins in rice (Oryza sativa L.). J. Exp. Bot. 2010, 61, 3971–3981. [Google Scholar] [CrossRef] [PubMed]
- Schütze, K.; Harter, K.; Chaban, C. Bimolecular fluorescence complementation (BiFC) to study protein-protein interactions in living plant cells. Methods Mol. Biol. 2009, 479, 189–202. [Google Scholar] [PubMed]
- Mersereau, M.; Pazour, G.J.; Das, A. Efficient transformation of Agrobacterium tumefaciens by electroporation. Gene 1990, 90, 149–151. [Google Scholar] [CrossRef]
- Livak, K.J.; Schmittgen, T.D. Analysis of relative gene expression data using real-time quantitative PCR and the 2−∆∆CT method. Methods 2001, 25, 402–408. [Google Scholar] [CrossRef] [PubMed]
- Su, Y.C.; Wang, Z.Q.; Li, Z.; Xu, L.P.; Que, Y.X.; Dai, M.J.; Chen, Y.H. Molecular cloning and functional identification of peroxidase gene ScPOD02 in sugarcane. Acta Agron. Sin. 2017, 43, 510–521. [Google Scholar] [CrossRef]
- Earley, K.W.; Haag, J.R.; Pontes, O.; Opper, K.; Juehne, S.; Song, K.; Pikaard, C.S. Gateway-compatible vectors for plant functional genomics and proteomics. Plant J. 2006, 45, 616–629. [Google Scholar] [CrossRef] [PubMed] [Green Version]
- Peng, Q.; Su, Y.C.; Ling, H.; Ahmad, W.; Gao, S.W.; Guo, J.L.; Que, Y.X.; Xu, L.P. A sugarcane pathogenesis-related protein, ScPR10, plays a positive role in defense responses under Sporisorium scitamineum, SrMV, SA, and MeJA stresses. Plant Cell Rep. 2017, 36, 1427–1440. [Google Scholar] [CrossRef] [PubMed]
- Lai, Y.; Dang, F.F.; Lin, J.; Yu, L.; Shi, Y.L.; Xiao, Y.H.; Huang, M.K.; Lin, J.H.; Chen, C.C.; Qi, A.H. Overexpression of a Chinese cabbage BrERF11, transcription factor enhances disease resistance to Ralstonia solanacearum, in tobacco. Plant Physiol. Biochem. 2013, 62, 70–78. [Google Scholar] [CrossRef] [PubMed]

© 2018 by the authors. Licensee MDPI, Basel, Switzerland. This article is an open access article distributed under the terms and conditions of the Creative Commons Attribution (CC BY) license (http://creativecommons.org/licenses/by/4.0/).
Share and Cite
Wang, L.; Liu, F.; Zhang, X.; Wang, W.; Sun, T.; Chen, Y.; Dai, M.; Yu, S.; Xu, L.; Su, Y.; et al. Expression Characteristics and Functional Analysis of the ScWRKY3 Gene from Sugarcane. Int. J. Mol. Sci. 2018, 19, 4059. https://doi.org/10.3390/ijms19124059
Wang L, Liu F, Zhang X, Wang W, Sun T, Chen Y, Dai M, Yu S, Xu L, Su Y, et al. Expression Characteristics and Functional Analysis of the ScWRKY3 Gene from Sugarcane. International Journal of Molecular Sciences. 2018; 19(12):4059. https://doi.org/10.3390/ijms19124059
Chicago/Turabian StyleWang, Ling, Feng Liu, Xu Zhang, Wenju Wang, Tingting Sun, Yufeng Chen, Mingjian Dai, Shengxiao Yu, Liping Xu, Yachun Su, and et al. 2018. "Expression Characteristics and Functional Analysis of the ScWRKY3 Gene from Sugarcane" International Journal of Molecular Sciences 19, no. 12: 4059. https://doi.org/10.3390/ijms19124059




